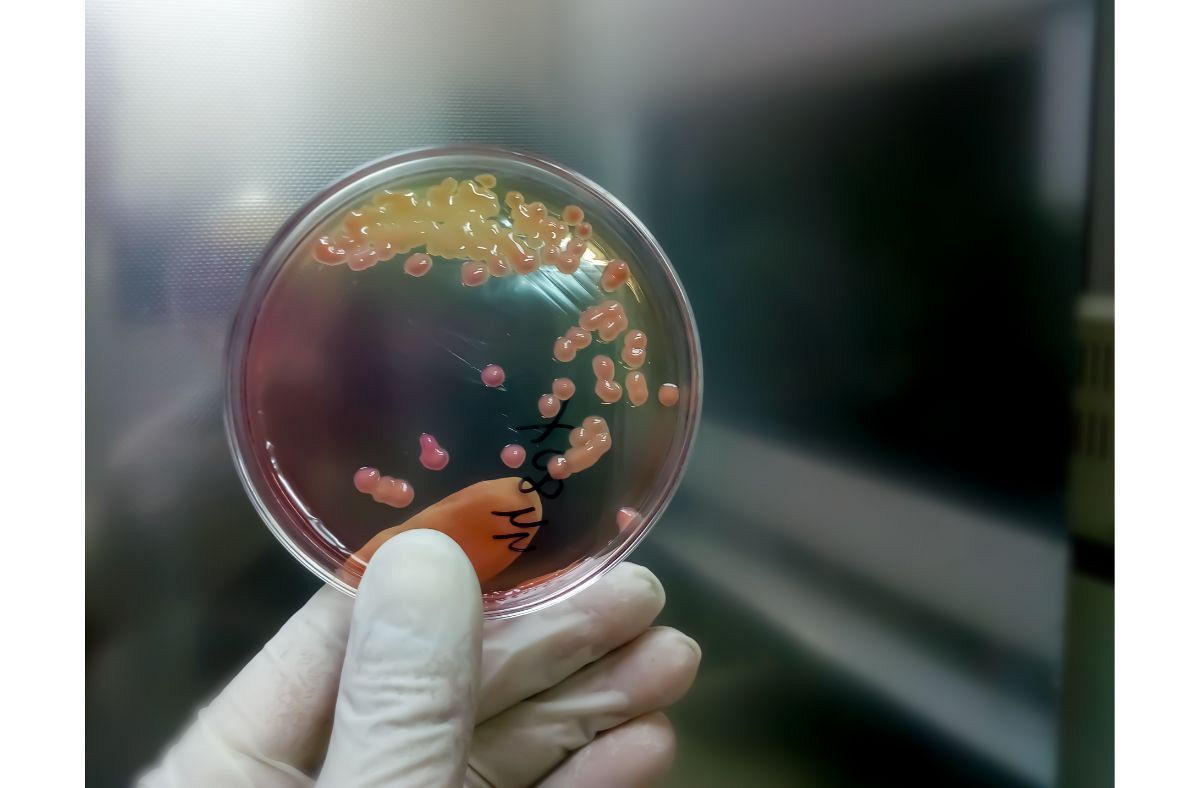

Il test di ricerca di sangue occulto nelle feci, chiamato dei “3 campioni”, riveste un ruolo fondamentale nei programmi di screening per il tumore del colon-retto. Viene raccomandato dai 45-50 anni in poi con cadenza annuale o biennale. Questa analisi, semplice e non invasiva, ha la finalità di identificare in modo precoce le persone a elevato rischio per questa neoplasia o per la presenza di polipi intestinali.
Bisogna però chiarire che la ricerca di sangue occulto non ha di per sé significato diagnostico: il suo scopo è individuare i soggetti che necessitano di ulteriori accertamenti di secondo livello.
Nel caso in cui dovessero evidenziarsi tracce di emorragia occulta, è indispensabile eseguire esami più approfonditi, come la colonscopia in sedazione, che mediante ispezione diretta della mucosa intestinale permette di rilevare eventuali lesioni proliferative e polipi, asportabili in una fase precoce prima che si evolvano in tumore.
Lo screening dei “3 campioni” è un esame tanto semplice quanto importante, perché strumento di diagnosi precoce e prevenzione. La raccolta dei campioni fecali per il test deve essere effettuata correttamente.
Generalmente sono fornite 3 provette contrassegnate, all'interno delle quali raccogliere parti diverse della stessa evacuazione utilizzando un bastoncino di legno o una spatola. I campioni devono essere prelevati a distanza di 24-48 ore l'uno dall'altro, preferibilmente nei giorni centrali del ciclo mestruale per le donne. Per ogni provetta è sufficiente 1 grammo circa di feci.
Importante evitare contaminazioni da sangue mestruale o urina. I campioni, debitamente sigillati, vanno poi consegnati al laboratorio di analisi nelle 24-72 ore successive la raccolta dell'ultimo. Eseguendo correttamente questi semplici passaggi è possibile ottenere campionamenti omogenei e attendibili per l'indagine di primo livello sulle perdite di sangue occulte nell'apparato gastrointestinale.